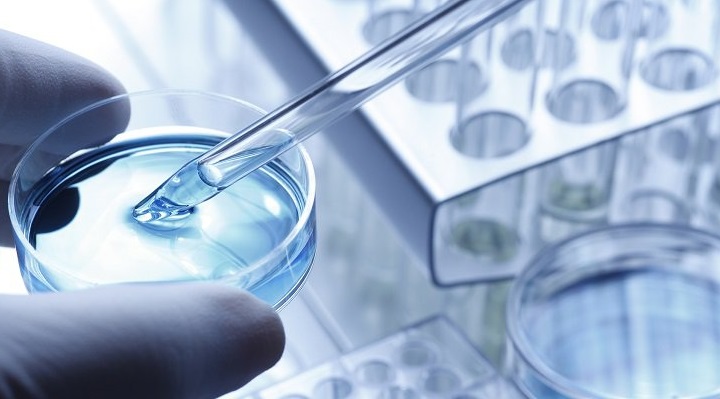
Ozempik

Етикети: европейско патентно ведомство
Проектът на ЕПВ беше представен по случай тазгодишния Международен ден на гората и Часът на Земята. Европейското патентно ведомство обяви, че ще обнови напълно сградата си във Виена в съответствие с най-високите екологични стандарти....
Европейското патентно ведомство ( ЕПВ )и град Мюнхен се срещнаха с млади иноватори по време на One Young World Summit между 22 и 25 юли. Делегатите присъстваха на поредица от речи, панели, събития в мрежа...
Президентът на Европейското патентно ведомство, като взе предвид чл.10(2)(a) и член 116 от Европейската патентна конвенция, реши, както следва: Член 1 Устни производства чрез видеоконференция пред правния отдел (1) Устните производства пред правния отдел...
Поради последното развитие на пандемията с COVID-19, Европейското патентно ведомство отново обръща внимание на правните средства за защита, предвидени от Европейската патентна конвенция (EPC) и съгласно Договора за патентно сътрудничество (PCT) в случай на...
От 14 септември 2020 г., Европейското патентно ведомство тества платформата Zoom за провеждане на устни производства при опозиции, включващи множество опоненти и / или при необходимост от симултантен превод. Това техническо развитие ще позволи...
Имайки предвид, че COVID-19 бе непознат до момента вирус, иновациите са един от най-добрите инструменти за борба с него. Технологии, които са разработени в отговор на по-ранни пандемии, напр. грипната пандемия от 1968 г.,...
В периода март-април 2020г. Европейското патентно ведомство проведе онлайн консултации с потребителите си. В следствие на получената обратна връзка и съответните изводи, представители на потребителски асоциации и експерти са провели 3 срещи с ръководството...
Компания: Asahi Kasei Kabushiki Kaisha, Япония Изобретение: Литиево-йонна батерия и нейната еволюция
В рамките на тазгодишното издание на Европейска награда за изобретател, Европейското патентно ведомство (ЕПВ) кани членовете си да гласуват за своя фаворит сред изобретателите, който да получи т.нар “Популярна награда”.
Вчера в Люксембург, в рамките на Съвета по конкурентоспособност, седем държави-членки (включително Франция, Германия и Обединеното кралство) са подписали Протокола относно временното прилагане на Споразумението за създаване на Единен патентен съд (UPC). Редица други държави...